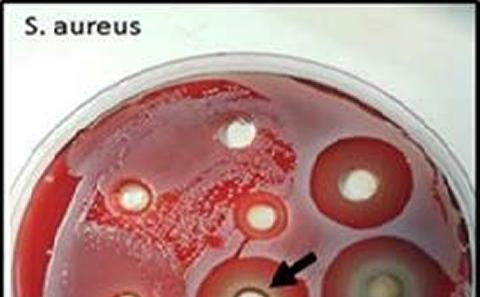
Culture plate

Preventing infections in orthopaedic implants
Uisng clay gels to deliver antimicrobial agents
Uisng clay gels to deliver antimicrobial agents

Cleaning and Simulating accelerated healing in wounds

Preventing the spread of infection in hospitals

Revolutionary cleaning technology

Finding new ways to prevent infection in urinary catheters

Studying the effect on contamination and decontamination of surgical instruments

We are developing a device to turn bottled water into an effective wound cleaner

New solutions to improve cleaning and reduce the risk of infection
.jpg_SIA_JPG_fit_to_width_MEDIUM.jpg)
Antibiotic resistant microorganisms cause great morbidity and mortality